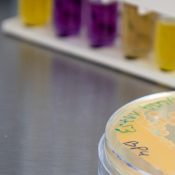
L&rsquo;université se dote d&rsquo;une cellule de production de ferments

En ce mois de janvier 2026, le Learning lab du CEMU est désormais officiellement labellisé par l’association LearningLab Network.
Le réseau LearningLab Network est un réseau francophone qui travaille sur les espaces d’apprentissage depuis 2014. Il réunit des acteurs et actrices de différents établissements du supérieurs engagés sur la question des espaces d’apprentissage et de la pédagogie. L’objectif du réseau est de promouvoir le Learning lab comme outil d’apprentissage.
Une démarche structurée et collective
La labellisation LearningLab Network repose sur une démarche exigeante, fondée sur l’analyse des usages réels des espaces d’apprentissage, de l’accompagnement des usagers et de la démarche réflexive de l’équipe en charge de l’animation du Learning lab. Pour obtenir la labellisation, il est nécessaire de couvrir sept des huit badges proposés par le réseau, le dernier badge est en bonus (« Contribue à la recherche scientifique »). Ainsi, le Learning lab du Cemu a obtenu les badges suivants :

Le Cemu s’est engagé depuis son arrivée sur le campus 1 en 2022 dans ce processus de labellisation avec une volonté claire : concevoir et animer un espace qui permet d’accueillir l’ensemble des enseignantes et enseignants souhaitant se former ou développer un projet pédagogique expérimental ou transformant. La démarche s’inscrit dans une dynamique d’amélioration continue.
Parmi les actions mises en place, nous avons installé du mobilier favorisant différentes postures de travail, assises comme debout, à partir des retours d’un groupe d’étudiantes et étudiants en M2 STAPS spécialité ergonomie, venus analyser des séances de travail. Dans un second temps, le Cemu a investi dans une installation de captation audio et vidéo automatique afin de faciliter le déploiement de la pédagogie co-modale et d’améliorer le confort d’écoute et de visibilité des usagers lors de la diffusion des contenus sur écran.
Afin de mieux accompagner le personnel souhaitant utiliser le Learning lab pour la première fois, nous avons élaboré une nouvelle signalétique visant à rendre plus lisibles les actions permises dans l’espace (séquencer les temps d’échanges et de déplacements, localiser le matériel disponible, etc.) en fonction du déroulé de la séance.
Avec l’obtention de sept badges, cette reconnaissance vient saluer un travail collectif de long terme autour de l’innovation pédagogique, de l’accompagnement des usagères et usagers et du développement d’un espace d’apprentissage ouvert, flexible et inclusif.
Explorer et diffuser de nouvelles actions
Le Learning Lab n’est pas seulement un lieu de formation ni une simple alternative à une salle de cours traditionnelle. Grâce à la présence, au sein du CEMU, d’un référent régional de l’association Learning Lab Network, la réflexion sur les espaces d’apprentissage devient également un terrain d’exploration et d’expérimentation.
À l’occasion des 10 ans de l’association, le Cemu a ainsi organisé deux séminaires intitulés Learning Lab Expedition, réunissant au total plus de 30 participantes et participants (enseignants-chercheurs, personnels administratifs, ingénieurs pédagogiques et formateurs). Ces rencontres, organisées sous forme de groupes de travail thématiques, avaient pour objectifs d’explorer les enjeux des espaces d’apprentissage inclusifs et de proposer des actions concrètes pour mieux accueillir l’ensemble des usagers, qu’ils soient issus de l’université ou extérieurs.
Dans la continuité de ces journées, un groupe de travail poursuit actuellement la réflexion en élaborant des supports et des outils visant à concrétiser les pistes identifiées.
À savoir
Les composantes de l’université disposant d’un espace d’apprentissage flexible et accueillant des activités pédagogiques diversifiées peuvent s’engager dans cette démarche de labellisation. Elle permet soit de valoriser le travail des équipes enseignantes, soit de donner un objectif collectif pour améliorer ou développer l’animation de leurs espaces.
Plus d’informations
Pour tout renseignement, contactez Gabin Mottais, Référent de l’association LearningLab Network Normandie : gabin.mottais@unicaen.fr
Retrouvez l’article sur notre labellisation sur le site internet du réseau LearningLab Network.
Retrouvez les actes du colloque LearningLab Network qui a eu lieu au Cemu en novembre 2025 sur le site dédié.





















































































![[En]Quête de Sciences](https://www.unicaen.fr/wp-content/uploads/2026/03/UNICAEN_SCD_banniere-enquete-de-science-2026-scaled-175x175.jpg)


























































![]interstice[, le festival international des arts visuels, sonores et numériques](https://www.unicaen.fr/wp-content/uploads/2025/12/Festival-Interstice-175x175.jpg)















































































































![Retour sur la Matinée Cyber [en] jeux](https://www.unicaen.fr/wp-content/uploads/2025/06/matinee-jeux-cyber-scaled-175x175.jpg)

![[En]Quête de Sciences 2024](https://www.unicaen.fr/wp-content/uploads/2024/03/UNICAEN_BANNIERE_ENQUETE_DE_SCIENCES1000x300--175x175.png)












































































































































































































































































































![Festival « [En]quête de sciences »](https://www.unicaen.fr/wp-content/uploads/2022/03/bandeau-enquetes-de-sciences-175x175.jpg)













































































































![[En]Quête de Sciences : 5e édition du festival de médiation scientifique](https://www.unicaen.fr/wp-content/uploads/2020/10/rs-enquete-de-science-175x175.png)























































































